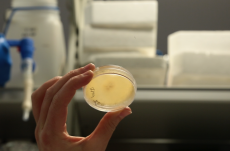
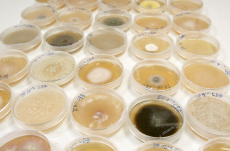

somewhere beyond right and wrong there is a garden. i will meet you there
curatorial project | symposium
Foraging Futures
workshop
teleconnections
curatorial project | exhibition
terramancy (working title)
artistic research / video essay
Almanac of Alternating Atmospheres
multimedia installation
Hindcast
artistic research / video essay
Hydrojustice (Hindcast Counter-Archives)
Grounding Biosphere.X
multimedia installation
souvenirs entomologiques (specimen)
installation
souvenirs entomologiques I: odonata / weathering data
video essay
geological correlations
workshop / walk
voicing encounters – a narrative cartography of virus
time image
video installation
proximity distance
video installation
horizon f(r)ictions
video installation
a line is a dot that went for a walk
video essay
frontier
video installation
a common ground
workshop
dialogue
video installation
song for the last queen
installation
fabric of time
installation
»1:x – the invisible part of the iceberg«
curatorial project | exhibition